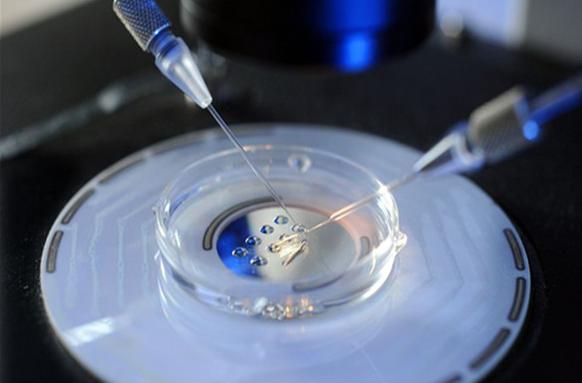
申请试管婴儿的证件？申请试管需要哪些证明？

更新时间:2023-11-07
试管婴儿技术是一种辅助生殖技术,可以帮助那些无法自然受孕的夫妇实现生育愿望。但是在申请试管婴儿时需要提供一系列证件,这让很多夫妇感到困惑。本文将解答在申请试管婴儿时需要提供哪些证件以及如何准备。
试管婴儿是指通过助孕怀孕技术将卵子和精子结合在实验室中,培养出胚胎后再将其移植到女性自己体内进行着床和分化发育,从而实现人工辅助生殖的技术。这项技术可以帮助那些因为身体原因无法自然受孕的夫妇实现生育愿望。
在申请试管婴儿时,通常需要提供以下证件:
以上证件主要用于确认夫妇双方的身份信息以及评估他们是否具备接受试管婴儿治疗的条件。此外在不同地区或不同医院可能还会有其他针对性的要求。
首先要确保所有相关证件都是有效且齐全的,如果有遗失或过期的情况需及时补齐或重新办理。其次在提交前要对所有资料进行核对和整理,确保没有遗漏或错误。比较后,在提交之前比较好先与医院沟通确认具体要求并按照规定进行准备。
小提示:申请试管婴儿需要提供一系列证件来确定夫妇双方身份信息以及评估他们是否适合接受治疗。这些证件助孕括:个人身份证明文件、结婚证明文件、医疗相关资料以及经济相关资料等。在准备这些材料时应注意确保其有效性和完整性,并与医院沟通确认具体要求后进行整理提交。
以上就是医院招聘网小编为大家整理的《申请试管婴儿的证件?申请试管需要哪些证明?》相关信息,希望大家喜欢。
内容版权声明:本网站部分内容由网上整理转发,如有侵权请联系管理员进行删除.